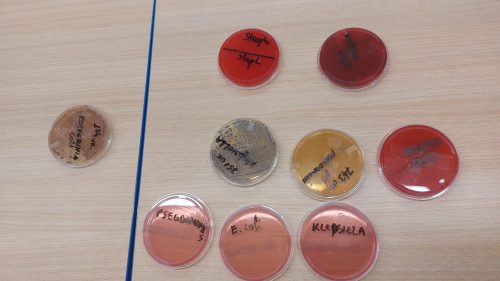
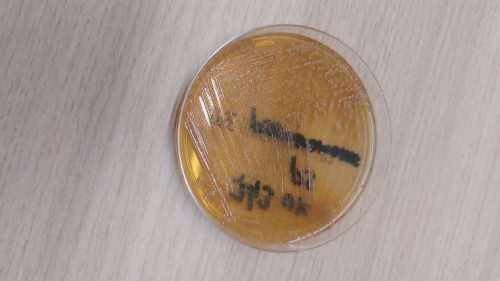

Pedijatri širom Srbije upozoravaju na širenje bakterije Pseudomonas aeruginosa, uporne infekcije koja može zahvatiti i decu i odrasle, a posebno je opasna za najmlađe. Ova bakterija je otporna na mnoge antibiotike i često se ne prepozna na vreme, jer njeni simptomi podsećaju na običnu virusnu infekciju.
– Pseudomonas aeruginosa najčešće se nalazi u mokraćnim putevima i jedan je od najčešćih uzročnika urinarnih infekcija. Simptomi su malaksalost, temperatura, gubitak apetita, pa roditelji često pomisle da je reč o virusu, – objašnjava pedijatar dr Saša Milićević.
Bakterija se najpreciznije otkriva analizom urina ili stolice, a nakon potvrde infekcije neophodno je uraditi antibiogram, kako bi se odredila tačna terapija. Lečenje traje od sedam do deset dana, a po završetku terapije obavezna je kontrolna analiza, jer se infekcija teško povlači.
Ukoliko se ne dijagnostikuje na vreme, Pseudomonas može da pređe u krvotok i izazove sepsu, što je stanje koje može biti životno ugrožavajuće.
Doktor upozorava i na posebne mere higijene, jer se bakterija lako širi u vlažnim sredinama i kontaktom među decom.
–Kupanje u istoj kadi treba izbegavati.Ukoliko ne možemo decu da kupamo odvojeno, u odvojenim kadama, onda se savetuje da se kada pre kupanja dobro ispere i opere, jer je higijena tada jako važna, -savetuje dr Milićević.
Zbog anatomske građe, devojčice su nešto podložnije infekciji, jer kraći mokraćni kanali omogućavaju da se bakterija brže proširi na gornje delove urinarnog trakta.
Lekari poručuju: pravovremena dijagnoza, stroga higijena i precizno sprovedena terapija ključ su u borbi protiv ove uporne bakterije.
Hypetv.rs/Espreso.co.rs/J.P.
BONUS VIDEO:
GLEDAJTE NAS!

Čitajte Hypetv.rs portal, najbrži portal u Srbiji i regionu sa najvećim rastućim rezultatima i ekskluzivnim vestima. Zapratite nas i na Instagramu, Facebook, Threads!













